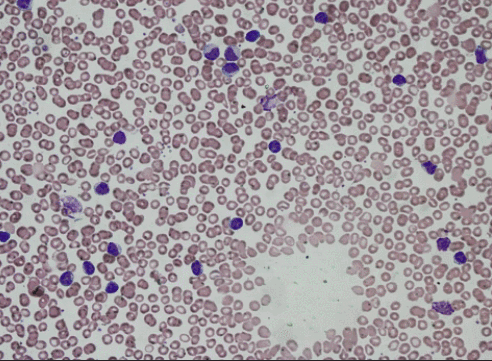
1686551313655087.gif 640.gif

最近,Am J Transl Res 雜志報道了一例病例:一名 50 歲的急性腎功能衰竭患者,伴有免疫球蛋白a腎病(IgAN)、肌酐水平升高(3.0 mg/dL)和高血壓。患者接受了總計 1.2 億個臍帶間充質干細胞(UC MSCs)的靜脈輸注,并接受了 6 個月的隨訪。結果顯示,在任何隨訪期間、之后或期間均未報告不良事件。治療 6 個月后,肌酐水平下降并保持正常(1.0 mg/dL),不再需要抗高血壓藥物。該病例表明,UC-MSC 給藥是安全的,耐受性良好,對患者有益。

IgAN 腎病是一種自身免疫性疾病,IgA 在腎小球中積聚,導致慢性炎癥。盡管有些病例可能多年無癥狀,只有在死亡后才能檢測到,但 IgAN 可能表現為其他患者可見的血尿、高血壓,或者在更嚴重的病例中,腎功能迅速喪失導致腎衰竭。在急性腎功能衰竭期間,腎功能的突然喪失與血清肌酐和電解質水平升高有關,也與體內廢物和病原體管理不當導致的全身炎癥增加有關。
目前,IgAN 的治療優先使用皮質類固醇和/或免疫抑制劑來降低循環 IgA,以及使用抗高血壓藥物來控制血壓。然而,考慮到 hUC MSC 給藥后患者腎臟狀況的改善,間充質干細胞的血管生成和再生特性也可能專門應用于腎衰竭引起的腎損傷。
50 歲男性患者接受 1.2 億臍帶間充質干細胞輸注
2019 年 12 月,一名 50 歲的男子在使用阿奇霉素治療上呼吸道感染后,出現持續的雙側側面疼痛、不適和腹瀉。他于 2020 年 1 月在美國尋求醫療援助。
實驗室分析顯示,肌酐水平(6.2 mg/dL)、c反應蛋白(74 mg/L)和鉀(6.4 mmol/L)增加。患者因高血壓入院,進一步檢查顯示患者患有 IgA 腎病。患者需要接受幾輪血液透析和環孢素治療,以及肺水腫和高血壓危象的治療。穩定后,患者出院時的肌酸酐水平為 3.0 mg/dL。
2020 年 3 月,患者接受了人臍帶間充質干細胞(hUC-MSCs)治療。由于在體檢中觀察到患者的血壓為 160/90 mmHg(重復后為 150/110),脈搏為 90 bpm,他還服用了阿達拉?硝苯地平治療高血壓。
患者在 3 天內共靜脈注射了 1.2 億個 hUC-MSC,并為此提供了書面知情同意書。給藥后立即測量生命體征,給藥后 30 分鐘繼續測量生命體征并記錄不良事件(如有)。此外,患者在治療后一個月、兩個月和六個月進行了隨訪。
接受干細胞治療后“感覺好多了”
接受 hUC MSC 治療后,患者對 hUC 間充質干細胞輸注表現出良好的耐受性,在給藥期間或給藥后或任何隨訪中均未報告不良事件。
在一個月的隨訪中,患者的血壓降至 130/80 毫米汞柱,他報告說感覺“好多了”。在 2 個月的隨訪中,血液測試顯示血紅蛋白為 15.3 g/dL,HCT 為 44.4%(表1)。在 6 個月的隨訪中,患者的病情持續顯著改善,血壓讀數正常(120/80 mmHg),肌酐水平維持在 1.0 mg/dL。同時,患者報告稱,由于血壓改善,他不再服用硝苯地平。
可以看出,UC-MSC 給藥對 IgA 腎病患者是安全、耐受性良好和有益的。接受 hUC MSC 治療后,患者對 hUC 間充質干細胞輸注表現出良好的耐受性,在給藥期間或給藥后或任何隨訪中均未報告不良事件。

表1:UC-MSC 給藥后的血紅蛋白、紅細胞壓積和血壓讀數

圖1:急性腎功能衰竭患者的肌酐水平(mg/dL)。腎衰竭發生于 2020 年 1 月,該患者于 2020 年 3 月接受了 1.2 億次 UC MSCs,并于 2020 年 5 月和 9 月進行了隨訪。
大多數急性腎功能衰竭患者(62%)在住院后不久或住院后幾個月內恢復到基線肌酸酐水平,但恢復正常腎功能可能需要長達一年的時間。肌酸酐水平升高的患者發生長期重大急性腎臟事件的風險更高。在本病例報告中,我們觀察到(圖1),在給予 hUC MSC 兩個月后,肌酸酐水平從升高(3.0 mg/dL)顯著降低到正常(1.03 mg/dL)。紅細胞壓積和血紅蛋白水平也有所改善(表1)。
該病例成功地用 UC-MSC 給藥治療了 IgA 腎病患者,希望能促進該領域的進一步研究。我相信,通過未來更大規模、盲法、安慰劑對照和隨機試驗,可以建立骨髓間充質干細胞在腎臟恢復中的抗炎和營養機制,使更多患者受益。
已有數千例患者證實間充質干細胞的潛力
眾所周知,間充質干細胞具有抗炎、抗凋亡和血管生成特性。在過去十年中,MSC 的管理已被證明是安全的。2012 年,對 1000 多名接受靜脈注射 MSC 治療的受試者進行的分析顯示,除一小群輕度發熱的受試對象外,未發現任何毒性或治療相關不良事件。

最近,對 2500 多名受試者的另一項分析證實了類似的安全性。在臨床前、體外和臨床研究中,間充質干細胞已被提議作為腎衰竭的輔助療法。與其他來源的間充質干細胞相比,來源于人臍帶的 hUC MSC 具有更大的增殖和擴增能力,增強了治療活性,刺激了生長因子的分泌,也具有治療潛力。
近年來,隨著新試驗數量呈指數級增長,越來越多的研究成果逐漸證明了間充質干細胞在臨床應用中的無限潛力。我們期待著更大規模的臨床試驗數據的發布,以促進該領域的臨床轉型。
免責聲明:
我們尊重原創,也注重分享。圖文來源網絡,版權歸原作者所有,如涉及作品內容、版權或其它問題,請聯系我們刪除!


 閩公網安備 35020602002648 號
閩公網安備 35020602002648 號 QQ 客服
QQ 客服
